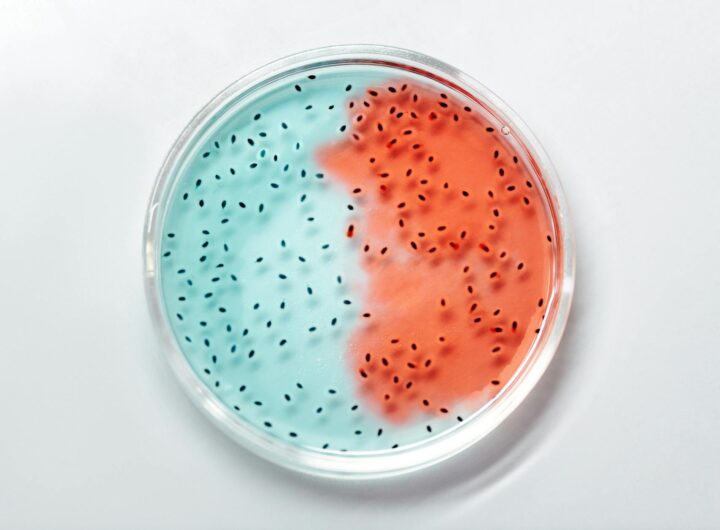

Remigiusz Jaworski
5 marca 2026
Organizacja przyjęcia komunijnego to wyzwanie, które wymaga starannego planowania i dbałości o szczegóły. Wybór cateringu może okazać...